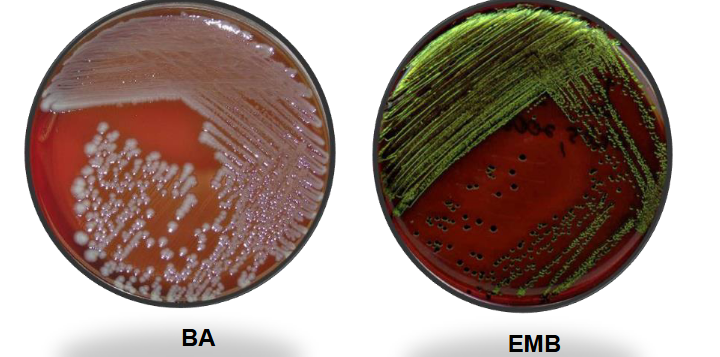
knowt flashcard image
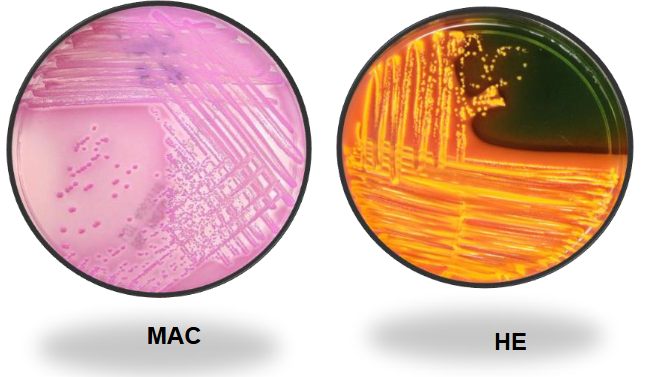
knowt flashcard image
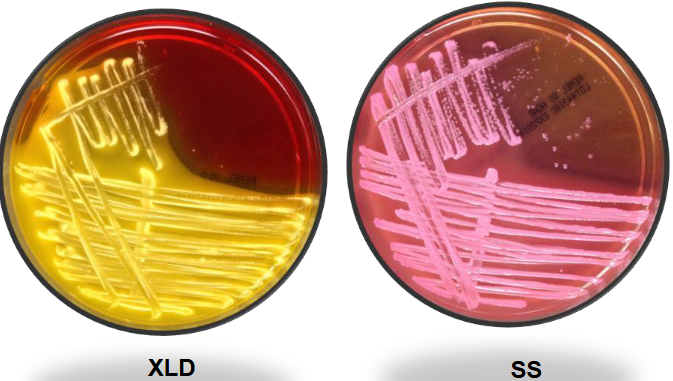
knowt flashcard image
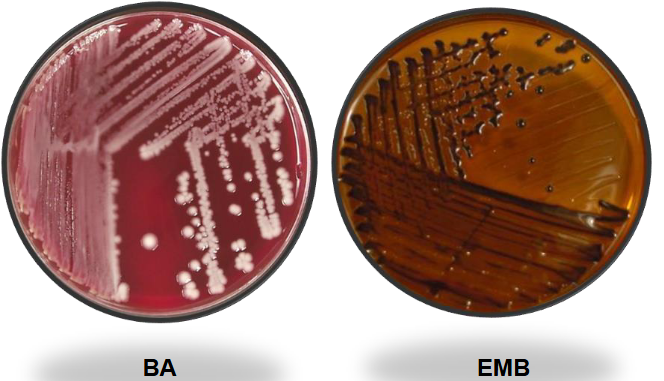
knowt flashcard image
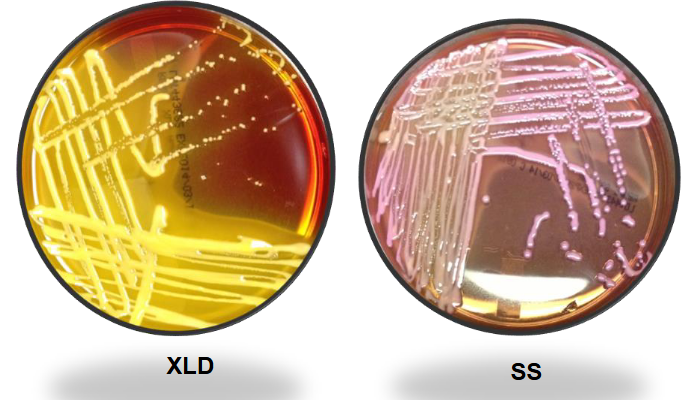
knowt flashcard image
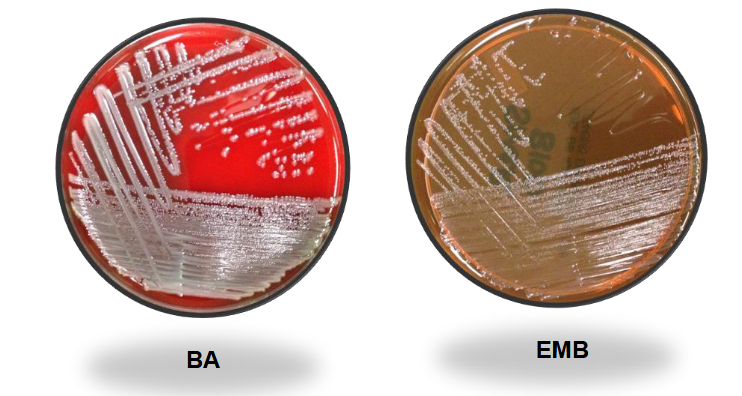
knowt flashcard image
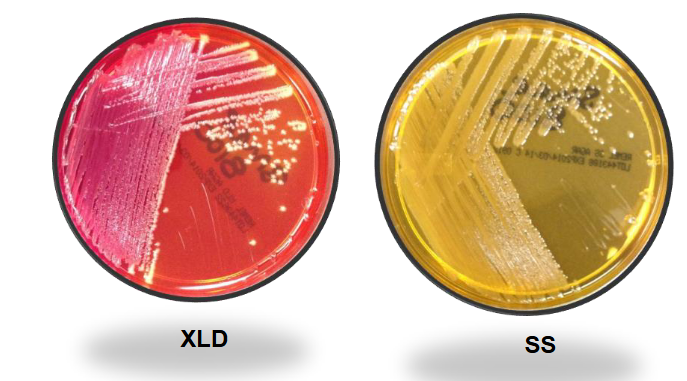
knowt flashcard image
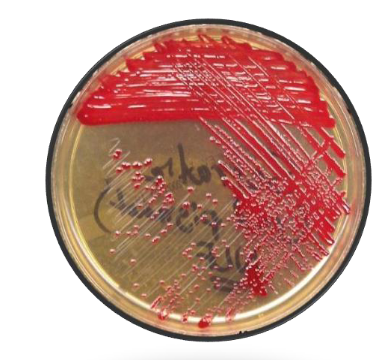
knowt flashcard image
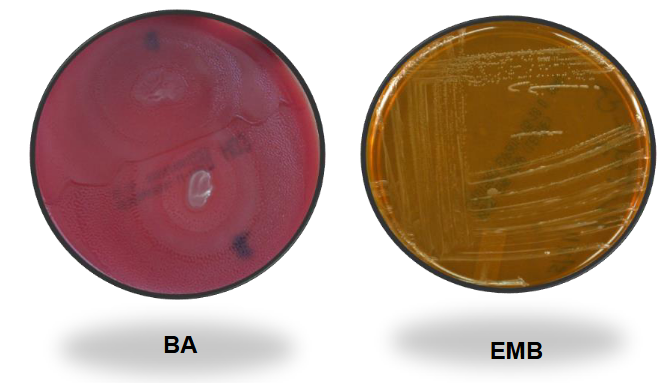
knowt flashcard image
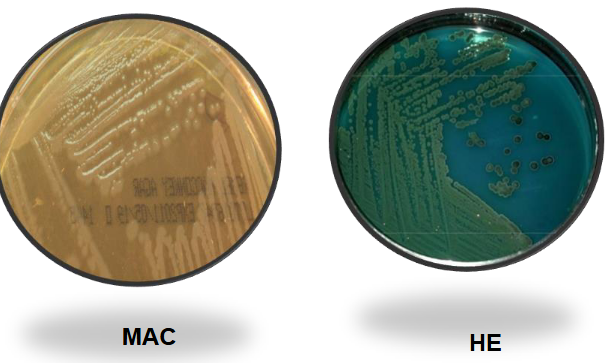
knowt flashcard image
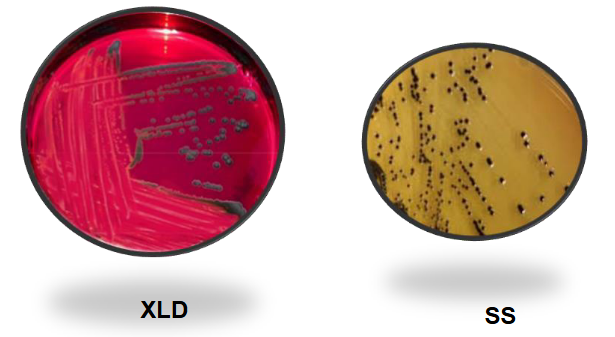
knowt flashcard image
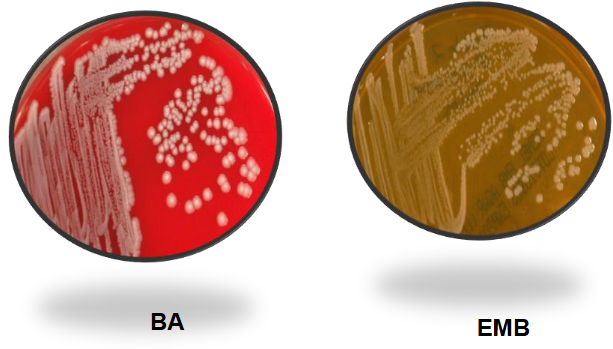
knowt flashcard image
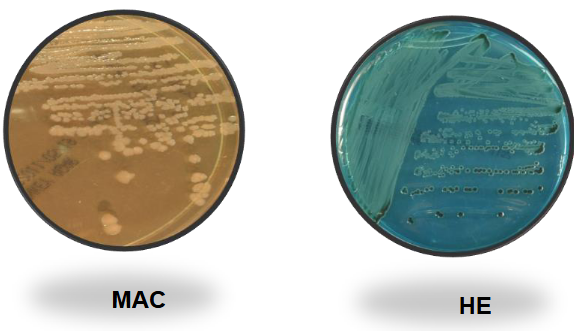
knowt flashcard image
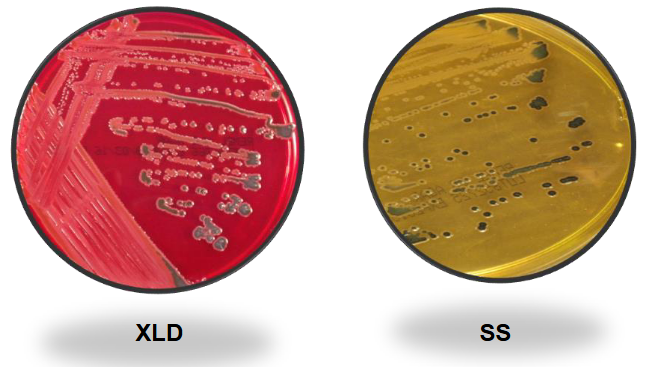
knowt flashcard image
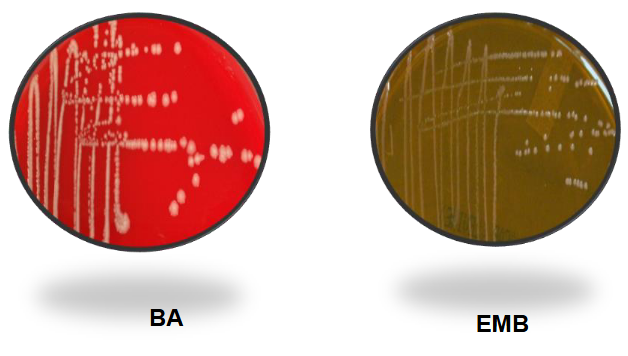
knowt flashcard image
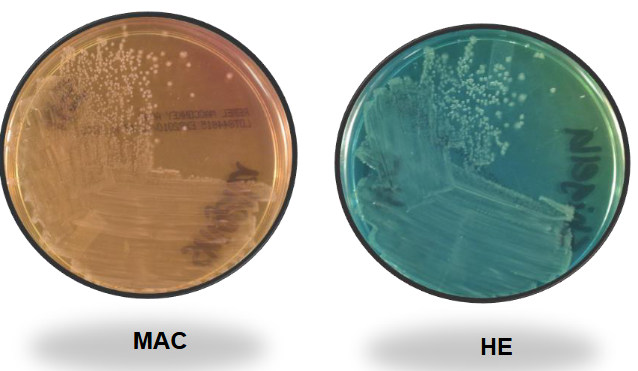
knowt flashcard image
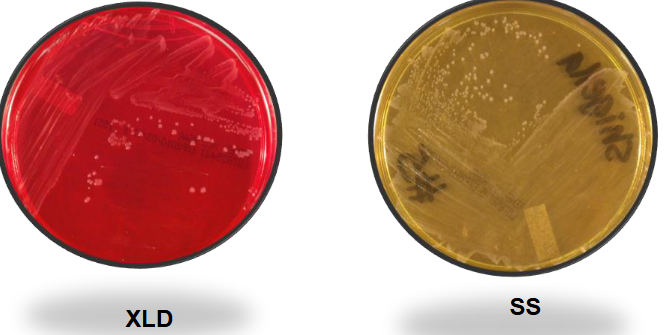
knowt flashcard image

1/134
Looks like no tags are added yet.
Name | Mastery | Learn | Test | Matching | Spaced | Call with Kai |
|---|
No analytics yet
Send a link to your students to track their progress
Neisseria spp. characteristic
Neisseriaceae family: Neisseria & Kingella
Moraxellaceae family: Moraxella & Acinetobacter
GS: Gram-negative cocci (GNC) in pairs (diplococci) with
flattened adjacent sides. “Kidney bean” or “coffee bean” shape.
Characteristics:
Capnophilic-Neisseria; aerobic-Moraxella
Nonmotile
Oxidase: positive
Normal habitat: All but GC normal flora of the upper respiratory tract
Neisseria gonorrhea
GC is short for Gonococcus.
Gram negative dipplo-cocci. (all pairs).
There is a lot of info, it is broken into separate questions/flashcards.
Once could ID GC (from urogenital specimens) based on:
Oxidase.
Typical gram stain.
Growth on gonococcal selective media.
Now recommended that all isolates be completely identified since other MO can meet above criteria.
Medicolegal cases (e.g., child abuse):
Perform TWO confirmatory tests.
Should be based on different methodologies.
Neisseria species from respiratory tract isolates presumptively ID by typical: Gram stain, colonial morphology.
N gonorrhea diseases
Gonorrhea: a sexually transmitted disease (STD).
Infected sites depend on sexual practices.
Symptoms: Males (approximately 95%). Females often asymptomatic (20%-75%).
Urogenital tract:
Males: Acute urethritis with purulent urethral discharge
Females: Cervicitis; many with urethritis. May spread up & cause pelvic inflammatory disease (PID) - NOTE: Other causes of PID include Chlamydia, trachomatis and normal vaginal flora.
Disseminated gonococcal infections (DGI):
Spread of untreated mucosal infections.
Usually bacteremia, septic arthritis, and skin lesions.
Other types of infections:
Pharyngitis.
Proctitis (infected anal canal).
Ophthalmia neonatorum (newborn eye infection) can be
caused by several MO including GC.
Antibiotic-resistant GC significant public health problem.
N. gonorrhea specimen collection
Appropriate specimens:
Infected body sites.
Do not use antiseptics or disinfectants on patients or instruments.
Dacron or rayon swabs preferred – some calcium alginate & cotton swabs are inhibitory
Specimen Transport:
Direct inoculation onto culture media best.
Put specimen onto culture media at bedside and Place in humidified CO2 environment & incubate (35 C).
Nonnutritive transport media: For swabs; hold at room temp.
Nutritive transport systems:
Examples: JEMBEC, Gono-Pak, & In-Tray GC.
GC agar medium + CO2 atmosphere.
N. gonorrhea culturing out the specimen
Culture media: GC needs enriched medium such as CHOC
Selective media (grow GC and N. meningitidis):
Enriched media (supply nutrients).
Antibiotics inhibit normal flora.
Examples: Modified Thayer-Martin (MTM)*, Martin-Lewis (ML)*, New York City (NYC), GC-Lect (GCL)*, (*Chocolate agar-based). Other MO may grow.
Some labs use both selective and nonselective media since
some strains inhibited by antibiotics (vancomycin).
Always include CHOC when culturing normally sterile
sites:
Will grow variety of MO
Will grow vancomycin (S) GC.
Prewarming to room temp enhances growth.
Incubation conditions:
Incubated at 35 C in humidified CO2 atmosphere for up to
72 hours; examine every 24 hours.
GC nonviable with long incubation (autolytic enzymes).
Colonial morphology (5 types):
T1 & T2 colonies: Small and raised; have pili.
T3, T4, & T5 colonies: Larger & flatter; no pili.
N. gonorrhea direct detection tests
Direct detection tests:
Gram-stained smears:
Smear preparation: Best if prepared immediately after specimen collection.
Smear examination: Low power for PMNs (100-fold magnification). Oil objective for intracellular Gram Neg diplococci.
Clinical applications:
Urethra from males: Excellent test
Endocervix: Sensitivity low; do culture.
Rectal and Pharynx swabs: Not appropriate; do culture.
Nucleic acid probe: Several types including DNA probe assay for GC in specimens, confirmation of GC isolates, & RNA hybridization specific for DNA sequences of GC.
Nucleic acid amplification tests (NAAT):
Consistently exceeded the sensitivities of other methods [direct probe (non-amplified) & culture].
Advantage is the ability to test for Chlamydia trachomatis from the same specimen at the same time.
Test NOT ADMISSIBLE as evidence in medicolegal cases.
Neisseria meningitidis
Normal habitat: Upper respiratory tract.
Diseases:
Meningococcemia, meningitis + other sites.
Petechiae (hemorrhagic skin lesions).
Treat close contacts prophylactically with antibiotics.
Vaccine available.
Specimen collection and transport:
Appropriate specimens: Any infected body site.
Transport immediately to lab; MO harmed by drying & refrigeration.
Direct detection tests:
Microscopic examination: Gram-stained smears.
Latex agglutination or coagglutination tests available (CSF, serum, & urine).
Many labs have discontinued offering tests routinely due to: High cost, Little diagnostic & prognostic utility after years of use, Best are results achieved with CSF; test may be available by request.
Recommended method is careful inspection of Gram-stained smear of cytocentrifuged specimen.
Cultures:
BAP, CHOC & selective gonococcal media.
Incubated at 35 C to 37 C with increased CO2 and humidity.
Other Neisseria spp. (lactomica)
Normal habitat: Upper respiratory tract and genitourinary tract.
Diseases: Usually do not cause disease.
Culture conditions: Not fastidious; most will grow on nutrient agar.
Tests to ID Neisseria spp.
GS
Oxidase
Carbohydrate utilization systems (ex: CTA, Rapid versions).
Chromogenic substrate tests (testing for: beta-galactosidase, beta-glutamylaminopeptidase, Hydroxyprolylaminopeptidase, Butyrate esterase).
Superoxol test
Also, molecular and immunologic tests (fluorescent ABY, coagulation tests).
Oxidase test principle
ALL NEISSERIA ARE OXIDASE POSITIVE
Principle: Detects cytochrome oxidase or indophenol oxidase. These enzymes transfer electrons to molecular oxygen..
Reagent: tetramethyl-p-phenylenediamine dihydrochloride.
Procedure:
Filter paper technique:
Saturate filter paper with liquid reagent.
Rub colonies onto the filter paper using stick or
platinum needle.
Agar plate: Drop oxidase reagent directly onto colonies.
Swab method: Collect colony on swab; add reagent.
Interpretation:
Positive: Dark purple or blue-black color 10-30 seconds. Colonies on agar plate turn pink first, then black
Negative: No color change.
Sources of error:
Results not valid for colonies growing on differential media
(EMB, MAC, etc.).
Loops & needles made of iron, stainless steel, or nichrome
may give false-positive results.
Other considerations:
With agar plate method, subculture when colony turns
pink; MO killed by oxidase reagent when colonies black.
Use fresh reagent, new each day.
Carbohydrate system test principle
Principle: Acid products are formed when carbohydrates are
used; phenol red detects pH change. Can ID MO based on carbohydrates metabolized.
1 carbohydrate (sugar) per tube. Typical panel: Glucose, maltose, lactose, and sucrose.
Procedure: Inoculate MO into test panel which includes negative
control (no carbohydrate) & incubate.
Interpretation:
Positive: Yellow (Acid produced).
Negative: Red (No acid produced).
Example systems:
Cystine trypticase agar (CTA): Traditional method.
Long incubation period (up to 3 days).
Based on growth - some strains grow poorly.
Rapid carbohydrate tests:
Check for preformed enzymes for sugar use.
Incubation for 1-4 hours.
Example: CarboFerm Neisseria Test.

Chromogenic substrate tests
Principle: Detect preformed enzymes. Colored end product formed when substrate hydrolyzed
Enzymes tested for include:
• Beta-galactosidase.
• Gamma-glutamylaminopeptidase.
• Hydroxyprolylaminopeptidase.
• Butyrate esterase.
Procedure:
Add MO to chromogenic substrate & incubate.
May need to add developing reagent.
Examine for color change.
Interpretation: Varies with system.
Test limitations: Presumptively identify N. gonorrhoeae, N. meningitidis, N. lactamica & Moraxella catarrhalis. To reduce possibility of misidentifying nonpathogenic species, test only GNDC (gram-negative diplococci) from gonococcal selective media.
Sources of error: Some nongonococcal Neisseria isolates may be
isolated on gonococcal selective media and misidentified as N. gonorrhoeae.

Superoxol test principle
Superoxol test:
30% H2O2 is used instead of the usual 3% H2O2.
Perform like catalase test.
GC produces immediate and vigorous bubbling.
Other Neisseria: Negative or weak, delayed reaction.
Moraxella catarhallis
Nomenclature:
Previously Neisseria catarrhalis and Branhamella catarrhalis.
M. catarrhalis only Moraxella that is a coccus. (rest are rods).
Normal habitat: Upper respiratory tract.
Diseases: Variety.
Culture conditions: Grows on BAP & CHOC; sometimes on GC selective.
Identification:
Asaccharolytic.
DNAse test:
Principle: DNAse enzyme cleaves deoxyribonucleic acid into nucleotide subunits.
Nucleotide subunits + toluidine blue = pink.
DNA + toluidine blue = blue.
Nitrate = Positive.
Butyrate esterase = Positive
Neisseria chart

Haemophilus spp characteristics
Gram stain: Haemophilus species are pleomorphic, gram-negative rods which are usually coccobacillary but on occasion may be filamentous.
Species isolated from humans include:
• H. influenzae
• H. parahaemolyticus
• H. parainfluenzae
• H. aegyptius
• H. haemolyticus
• H. ducreyi
• A. aphrophilus (new genus Aggregatibacter).
NF: Most are normal flora of upper respiratory tracts of humans and animals. H. ducreyi & H. aegyptius: NOT normal flora.
Hemolysis: beta or gamma, find by growing on horse/rabbit BAP, satellite on sheep BAP.
What are the haemophilus nutritional requirements?
Haemophilus = Greek for “blood loving”.
All (except some A. aphrophilus) require X factor and/or V factor:
Found in RBC:
X factor = hemin.
V factor = nicotinamide-adenine dinucleotide (NAD).
Growth on different types of blood agar:
Will grow on rabbit BAP & horse BAP.
Won’t grow on sheep BAP.
Sheep RBCs have NADase, which destroys NAD.
V factor requiring Haemophilus grow on sheep BAP only if NAD supplied by another organism (staphylococci).
Haemophilus satellites around NAD-producing colonies.
Other media: Grows on CHOC & some other enriched media.
Haemophilus colony conditions
Facultative anaerobe.
Grows in capnophilic, humidified atmosphere at 35 to 37C.
Most grow overnight; colonies may have a “mousy” odor.
H. aegyptius may need longer incubation.
H. ducreyi has special culture conditions.
H. influenzae
Most important spp, Antibiotic resistance is common.
Serotypes:
Based on polysaccharide capsule.
Types: a, b, c, d, e, or f.
Methods: Agglutination; coagglutination for H. flu type b (Hib).
Unencapsulated strains = nontypeable.
Biotypes: (I-VIII); based on biological tests.
H. influenza diseases
Hib once leading cause of serious disease (meningitis, osteomyelitis, epiglottitis & bacteremia) in children < 2 years old. Hib vaccine dramatically decreased incidence.
Non-typeable infections common (otitis media, sinusitis, & pneumonia).
H. aegyptius: closely resembles biotype III strains of H. influenza;
important cause of “pinkeye” = conjunctivitis.
H. influenzae specimen transport
Appropriate specimens: Infected body sites.
Use transport media for swabs.
Keep all specimens at room temperature & process ASAP.
Media: Include CHOC in media panel; CHOC + bacitracin improves
recovery from respiratory tract - bacitracin inhibits some normal flora
MO.
How is H. influenzae directly detected?
Microscopic examination of specimens:
Gram stain: Stain faintly & may be missed.
Acridine orange stain more sensitive method.
Antigen detection: Latex agglutination & coagglutination kits for Hib
capsular antigen in CSF, serum, and urine.
H. ducreyi
Disease:
Chancroid or “soft chancre”.
Sexually transmitted; several U. S. outbreaks.
Painful genital ulcers.
Buboes (swollen lymph nodes containing pus) in the groin.
NOTE: Chancroid caused by H. ducreyi & Chancre (syphilis) by Treponema pallidum.
Specimen collection, transport, and processing:
H. ducreyi very fragile.
Use saline moistened swab to collect material from base of genital ulcer.
Bubo aspirates may also be cultured.
Inoculate immediately onto appropriate media (e.g., enriched CHOC).
Vancomycin usually included in media to inhibit contaminants.
Incubate in high humidity CO2 atmosphere at 33 to 35C up to 5 days.
Direct examination: Gram-stained smear of lesion material may reveal “school of fish” (groups of gram-neg coccobacilli in a characteristic cell arrangement).
Other spp. of haemophilus
H. parainfluenzae, H. haemolyticus, H. parahaemolyticus, & A. aphrophilus (Aggregatibacter aphrophilus).
Normal flora of upper respiratory tract.
Usually nonpathogenic although can cause variety of infections.
Paper disks/strips Growth requirement tests for haemophilus
Haemophilus will grow on an agar lacking X & V factor if paper strips/disks impregnated with X factor or V factor are placed on agar surface.
Procedure:
Make suspension of MO in saline or in broth (without X &
V factors) (i.e., trypticase soy broth).
Swab MO onto agar plate without X & V factors (e.g.,
trypticase soy agar or Mueller-Hinton agar).
Put paper strips/disks with X factor or V factor onto agar
surface 1-2 cm apart. Some include strip/disk with X&V.
Incubate overnight in CO2 at 35 C & examine for growth.
Interpretation:
Growth around V factor strip/disk: MO needs only V factor.
Growth around X factor strip/disk: MO needs only X factor.
Growth between 2 strips: MO needs X & V factors.
Source of error: Carry over.
Do not transfer nutrients from CHOC to test media.
Best if use broth suspension to inoculate agar.
Quadrant plates for haemophilus growth requirements
Sections - Media with:
X factor.
V factor.
X & V factors.
Horse blood (for hemolysis).
Inoculate each section with MO & incubate
Porphyrin test
Determines if isolate requires X factor.
More reliable than strip test.
Principle: Species which do not need X factor have enzymes which
convert aminolevulinic acid (ALA) to hemin.
Porphobilinogen & porphyrins are intermediate
metabolites.
ALA → Porphobilinogen → Porphyrins → Hemin.
Porphyrins fluoresce reddish-orange when exposed to
ultraviolet light emitted by Wood’s lamp.
Porphobilinogen + p-dimethylaminobenzaldehyde
(Kovac’s reagent) = red color.
Procedure:
Add MO to tube with ALA.
Incubate several hours.
Check tube with Wood’s lamp or Kovac’s reagent.
Interpretation:
Wood’s lamp:
Reddish-orange fluorescence = positive.
MO converts ALA to hemin, it does not need X factor.
No fluorescence = negative result.
MO does not have enzymes to make hemin. It needs X factor.
Kovac’s reagent:
Red color = positive test.
MO can produce hemin, it does not need X factor.
No color change = negative test.
MO cannot make hemin, it needs X factor.
Other ID methods for Haemophilus
Biochemical identification by conventional methods or commercial kits.
Nucleic acid probe for Hflu ID.
Haemophilus spp. chart

Haemophilus spp. summary chart.

E. coli on Mac and EMB
E. coli on MAC and HE
E. coli on XLD and SS
Klebsiella pneumo BAP and EMB
Kleb pneumo on MAC and HE

Kleb pneumo on XLD and SS
Serratia marcancens (non pigmented) on BAP and EMB
Serratia marcancens (non pigmented) on MAC and HE

Serratia marcescens (non-pigmented) on XLD and SS
Pigmented Serratia on TSA (not all strains are pigmented)
Proteus Mirabilis on BAP and EMB
Proteus mirabilis on MAC and HE
Proteus mirabilis on XLD and SS
Salmonella on BAP and EMB
Salmonella on MAC and HE
Salmonella on XLD and SS
Shigella on BAP and EMB
Shigella on MAC and HE
Shigella on XLD and SS
TSI A/A

TSI A/A H2S

TSI K/A

TSI K/A H2S

TSI K/NC (non-fermenter)

SIM agar

Voges proskauer

Phenylalanine deaminase

Citrate

ONPG

Urea

DNAse

Lysine deoxycarbolase

LIA K/K

LIA K/K H2S

LIA R/A

LIA K/A

Enterobacterales characteristics
Gram stain: Gram-negative rods with straight sides and rounded ends. May exhibit bipolar staining (gram variable, both pos and neg staining).
Culture conditions: Facultatively anaerobic. Grows readily on routine laboratory media.
Normal habitat: Wide distribution. Intestinal tract normal flora in humans & animals.
Antigens:
“O" antigens: Somatic (body) antigens (part of cell wall), Heat stable, Used in ID some enterics (e.g., Salmonella and Shigella.).
"H" antigens: Flagellar; heat labile.
"K" antigens: Capsular; heat labile.
"Vi" antigen: Capsular antigen in some strains of Salmonella (e.g., S. typhi). Antigen present in some Citrobacter isolates.
Biochemical reactions common to nearly all enterics:
Glucose fermenters.
Oxidase: Negative (exception: Plesiomonas shigelloides).
Nitrate reduction: Nitrate is reduced to nitrite.
Enterobacterales names
Order: Enterobacterales.
Commonly referred to as “Enterics”.
Divided into 7 families:
Enterobacteriaceae.
Morganellaceae.
Yersiniaceae.
Erwiniaceae.
Budviciaceae.
Pectobacteriaceae.
Hafniaceae.
What are the bacteria’s included in the Escherichieae?
E.coli
E. coli O157:H7
E. coli K1
Shigella
E. coli characteristics
Most common Escherichia species.
Normal habitat: Predominant facultative GNB human GI tract..
Diseases:
Urinary tract infections (UTIs) - 90%.
Bacteremia - Especially if patient has UTI.
Meningitis in newborns.
Diarrhea: Variety of mechanisms; Traveler’s diarrhea
Colony: beta hemolytic.
E. coli O157:H7
Enterohemorrhagic E. coli.
Produces verotoxins (they damage vero cells) – closely related to
Shiga toxin produced by Shigella dysenteria.
Refered to as Shiga-toxin 1 and Shig-toxin 2.
Infections asymptomatic to fatal:
Hemorrhagic colitis (severe bloody diarrhea).
Hemolytic uremic syndrome (HUS).
Cultures:
Screen with Sorbitol-MacConkey (SMAC) (has sorbitol instead of the lactose found in routine MAC).
E. coli O157: Sorbitol (0) & colonies colorless.
Most other E. coli strains sorbitol (+) & red colonies.
Enterohemorrhagic E. coli non-O157 strains (non-O157 STEC):
Many facilities have eliminated the use of SMAC.
Other serotypes are capable of producing HUS (e.g., 0111:NM, 026:H11, 0145:NM, etc.).
Physicians request “detection of Shiga-toxin producing E. coli”.
Methods for detection include PCR, cytotoxicity assay, or EIA.
E. coli K1
Highly virulent due to the K1 capsular polysaccharide.
Associated with Extraintestinal Pathogenic E. coli (ExPEC) infections:
Common cause of neonatal meningitis.
Septicemia.
Pyelonephritis.
Methods for detection include PCR.
Shigella
4 spp., each with a serotype based on O antigens:
S. dysenteriae (A).
S. flexneria (B).
S. boydii (C).
S. sonnei (D).
Normal habitat: Shigella is not a normal flora.
Diseases: Shigellosis (bacillary dysentery):
Most U.S. cases caused by S. sonnei and S. flexneri.
Fecal-oral route of transmission.
4Fs: Food, feces, fingers, flies.
Most often in young children.
Identification:
Biochemical & serological tests.
Isolates with Shigella biochemical profiles tested with Shigella antisera.
Use bacterial agglutination tests.
If no agglutination, repeat test after boiling isolate for 15-30
mins (inactivates capsule which may mask “O” antigen).
Report as Shigella flexneri, etc. if agglutination.
Edwardsiella tarda
Most often isolated Edwardsiella species.
Found in the environment & associated with cold-blooded animals (i.e.,snakes, turtles, etc.,).
Human infections:
Relatively uncommon.
Can cause diarrhea, wound infections, and bacteremia.
Salmonelleae
Taxonomy: One genus & one species with many subspecies. Currently one species is Salmonella enterica.
Serogroups (A, B, C1, C2, D, E, G, and H) based on O antigens. 2200 serotypes based on O, H, and Vi antigens.
Serotype nomenclature:
Complex. Simplified version widely used.
Salmonella enterica, serotype Typhimurium is usually reported as Salmonella Typhimurium.
Normal habitat: Most species found in the intestinal tract of animals
b) Some (e.g., S. Typhi) only in humans (may be asymptomatic carrier).
Diseases:
Gastroenteritis (type of food poisoning).
Enteric fever.
S. Typhi (typhoid fever).
More severe form of enteric fever.
“Rose spots” (i.e., red lesions on the abdomen).
Blood cultures (+) during the first week of illness. Urine & stool cultures (+) 2nd & 3rd week.
S. Paratyphi A or B (Paratyphoid fever).
S. Choleraesuis.
Other infections caused by Salmonella include bacteremia,
osteomyelitis, meningitis, and endocarditis. Immunocompromised
patients are at increased risk.
Identification:
Serogroup isolates with biochemical profile of Salmonella.
Use antisera (i.e., A, B, C1, C2, D, E, G, H, and Vi).
Boil & retest organisms which do not agglutinate in an antiserum.
Isolates which agglutinate in an antiserum to a specific serogroup may be presumptively identified (e.g., Salmonella group B).
Serotyping: Performed by public health labs (e.g. Salmonella Typhimurium). Important epidemiologic tool.
Citrobactereae
One genus, Citrobacter (Related to Salmonella).
Most important species:
C. freundii.
C. koseri.
Klebsiella
K. pneumoniae:
Most commonly isolated.
Distinctive mucoid colonies on MAC & EMB
K. oxytoca also significant pathogen.
K. aerogenes (previously Enterobacter aerogenes).
Enterobacter cloacae
Was in the lecture manual with nothing else.
Serratia
Several species:
S. marcescens. Most commonly isolated.
Some have characteristic red to pink pigment.
Hafnia: H. alvei once classified as an Enterobacter
Pantoea: P. agglomerans once classified as an Enterobacter.
Colonies: pink pigment
Procteaceae
Proteus: Most important are P. vulgaris and P. mirabilis.
Both distinctive odor (“burned chocolate”).
Both “swarm”.
Providencia: P. rettgeri, P. alcalifaciens & P. stuartii most important.
Morganella has one species, M. morganii.
Plesiomonas shigelloides:
Gram stain: Straight gram-negative rods.
Habitat: Environment (soil & water).
Transmission: Commonly through contact w/ fresh water &
cold-blooded animals.
Diseases: Diarrhea most common disease.
Specimens: Stool + infected body sites.
Culture: Grows under routine lab conditions on BAP & MAC. Swarming
Identification: Oxidase: Positive - only member of family that is OX +. Carbohydrate utilization: Ferments glucose (some also ferment lactose).
Yersinieae (one genus, Yersinia)
Y. pestis
Y. enterolitica
Y. pestis
Disease: Plague.
Endemic in U.S. west and southwest.
Transmission: Infected flea bite or handling infected animal.
Bubonic plague: Fever and swollen lymph nodes (buboes).
Pneumonic plague: Respiratory tract infection.
Important pathogen on the list of bioterrorist agents.
Specimens: bronchial wash, blood or aspirate of tissue such as buboes.
Laboratory hazard:
Wear PPE (gowns and gloves).
Work in a biosafety cabinet.
Decontaminate work areas.
BSL-3 recommended for culture manipulations.
Presumptive identification:
Gram stain:
Gram-negative rods.
Bipolar staining (safety-pin appearance) may be seen but not unique to Y. pestis.
Colonial growth:
Grows well but slowly on BAP; pinpoint, gray-white, non-hemolytic at 24 hrs.
Non-lactose fermenter on MAC at 48 hrs.
Grows at 35-370 C, faster at room temperature.
Tests:
Oxidase -
Catalase +
Urea -
Indole -
NOTE: Automated identification systems often key out as non-Y. pestis (e.g. Shigella, H2S-negative, Salmonella, etc).
Threat assessment of plague: Identification of Y. pestis is considered presumptive until confirmed by the state health department. If Y. pestis is suspected from presumptive test results, the healthcare provider & state public health staff must be notified &
the isolate identification confirmed by the state health
department.
NAAT ID available.
Y. enterolitica
Diseases:
Enterocolitis: Most common manifestation. May resemble acute appendicitis
Extraintestinal infections:
Bacteremia.
Some traced to contaminated blood transfusion.
Laboratory aspects:
Grows readily on routine laboratory media.
Cefsulodin-irgasan -novobiocin (CIN) agar.
Enhances recovery.
Selective and differential medium.
Inhibitory substances: Antibiotics: Cefsulodin, irgasan & novobiocin. Bile salts & crystal violet.
pH indicator (neutral red) turns red/pink if mannitol fermented.
“Bull’s eyes” colonies: Red centers and clear edges.
Incubated for 48 hours at 22 to 25C.
Miscellaneous enterics
Budvicia
Obsumbacterium
Buttiauxella
Pragia
Cedecea
Photorhabdus
Ewingella Rahnella
Kluyvera
Tatumella
Leckercua
Trabulsiella
Lemiorella
Xenorhabdus
Moellerella
Yokenella
Enteric groups: Enterics not yet assigned genus and species name. Referred to as “enteric group 58”, “enteric group 59”, etc.
What is the growth on BAP for most enterics
Large, moist, gray colonies.
What are XLD and SS used for?
Thy are stool agars.
EMB agar purpose
Purpose: Selective & differential.
Inhibits gram (+); some staph & strep form small colonies.
Allows growth of hardy GNR.
Differentiates lactose (+) & (0) enterics.
Key components: Levine formulation.
Inhibitors and pH indicators: Eosin and methylene blue.
Carbohydrate: Lactose.
Colonial morphology:
Lactose fermenters:
E. coli: Usually strong lactose fermenter → green sheen.
Klebsiella: Produce blue-black colonies.
K. pneumoniae: Very mucoid.
Lactose nonfermenters: (Shigella and Salmonella) colorless.
Sucrose modification: Some labs use EMB with lactose & sucrose
MAC agar
Purpose: Selective & differential.
Key components:
Inhibitors: Bile salts & crystal violet.
pH indicator: Neutral red; neutral red is red/pink at an acid pH.
Carbohydrate: Lactose.
Colonial morphology:
Lactose fermenters:
E. coli, Klebsiella, & Enterobacter: Typically red/pink colonies surrounded by precipitated bile
(3) K. pneumoniae colonies very mucoid
b)
Lactose nonfermenters
(1) Salmonella, Shigella, & Proteus
(2) Colorless colonies
Salmonella Shigella (SS) agar
Purpose: Differential & selective.
Isolation of Salmonella and Shigella.
Inhibits gram (+) & many GNR (including some of Shigella).
Key components:
Inhibitors: Bile salts & sodium citrate.
pH indicator: Neutral red.
Carbohydrate: Lactose.
Hydrogen sulfide (H2S) system: Sulfur source (Sodium thiosulfate), Iron-based H2S detector (Ferric citrate), Black precipitate formed when H2S combines with iron.
Colonial morphology:
Lactose fermenters:
E. coli, Klebsiella, & Enterobacter.
Reduced growth & red/pink colonies.
Lactose nonfermenters:
H2S negative: Shigella produce colorless colonies.
H2S positive: Salmonella & Proteus usually colorless with black centers.
NOTE: The pH indicator in SS agar (i.e., neutral red) is the same as that in MAC. Lactose-positive organisms are red/pink on both media although growth may be slight on SS agar.
Hektoen enteric (HE) agar
Purpose: Differential & selective medium.
For isolation of Salmonella and Shigella (Good for Shigella).
Inhibits gram (+) bacteria & some GNR.
Key components:
Inhibitor: Bile salts.
pH indicators:
Acid fuchsin and bromthymol blue.
Uninoculated HE: Green.
Medium becomes yellow, orange, or salmon pink with acid.
Carbohydrates:
Lactose, sucrose, and salicin.
Acid made if one or more of sugars used.
Salmonella and Shigella usually (0).
H2S system: Sodium thiosulfate & ferric NH3 citrate.
Colonial morphology:
Lactose fermenters:
E. coli, Klebsiella, & Enterobacter.
Colonies: Large, yellow to salmon color.
Lactose nonfermenters:
Shigella: Green colonies (color of uninoculated HE agar).
Salmonella: Blue-greem colonies - black centers (H2S +).
Proteus: Blue-green or salmon, Proteus lactose Neg, Some sucrose and/or salicin Pos.
Proteus & Salmonella often distinguished on HE, Not SS agar.
Xylose-lysine-Deoxycholate agar (XLD)
Purpose: Differential & selective.
Isolation of Salmonella and Shigella.
Inhibits gram-positive bacteria and some gram-negative rods.
Key components:
Inhibitor:
Sodium deoxycholate (i.e., bile salts).
Lower concentration: Less inhibitory than HE & SS agars.
pH indicator:
Phenol red.
Uninoculated XLD = red.
Yellow color if acid formed.
Carbohydrates:
Lactose, sucrose, & xylose.
Most enterics ferment xylose and turn the medium yellow.
Shigella is xylose negative.
Lysine:
Salmonella: Lysine decarboxylase positive.
Alkaline metabolites formed when lysine decarboxylated &
medium turns red.
Although Salmonella is xylose positive, its lysine metabolism (and resultant alkaline products) counteracts the acid produced from xylose.
H2S system: Sodium thiosulfate & Ferric NH3 citrate.
Colonial morphology:
Lactose fermenters:
E. coli, Klebsiella, & Enterobacter.
Large & yellow in color.
Lactose nonfermenters:
Shigella: Red colonies (same color as uninoculated XLD).
Salmonella: Red with black centers (lysine & H2S Pos).
Proteus: Red to yellow; often with black centers.
NOTE: Phenol red is a commonly used pH indicator in the clinical laboratory. Examples include mannitol salt agar for staphylococci and CTA sugars for Neisseria identification. It is red when alkaline and yellow in acid.
Brilliant green/bismuth sulfite (BS) agar
highly selective for isolation of Salmonella
What are the enrichment broths?
Fecal specimens contain many organisms.
Used to enhance recovery of Salmonella and Shigella.
Inhibit growth of unwanted organisms.
Selenite broth.
Gram negative broth (GN).
Selenite broth
Good for isolation of Salmonella when contamination heavy.
Sodium selenite inhibits other enterics..
Need 2-inch-deep broth (Best results if conditions anaerobic).
Subculture after 8-12 hours onto enteric media.
Gram negative broth
Deoxycholate (bile) & citrate inhibitors: Low concentration, Less inhibitory.
Mannitol concentration > glucose:
Salmonella & Shigella aided since they ferment mannitol.
Proteus inhibited since it does not ferment mannitol.
Subculture (after 4-6 hr incubation) onto enteric media.
Chemical ID tests for the enterics
Carb utilization
ONPG test
H2S production
KIA
TSI
Indole
MR and VP
Citrate utilization test
Phenylalanine deaminase test
Deoxycarbolase-dihydrolase test
LIA
Urease test
Motility
MUG test
Combination media tests
What are the automated systems for ID?
Vitek
MicroScan
BD Phoenix
VersaTrek
MALDI-TOF
Mass spectrometry is a technique for determining the elemental composition of a sample.
Using this method patterns of proteins are detected directly from bacteria.
The patterns are compared with a database of clinical bacterial isolates to determine identification.
Test is extremely rapid - average time per isolate in published reports is 4-6 minutes.
Carb utilization meaning in Micro
“Fermentation” has two different meanings in clinical microbiology.
Strict definition: Fermentation: Anaerobic metabolic process. Example: E. coli is a glucose fermenter because it can
metabolize glucose anaerobically.
“Fermentation of sugars” (Loosely used term) = Some MO called fermenters when acids made from carbohydrates. Example: E. coli is “lactose fermenter” because it produces acid from the lactose in enteric media (e.g., MAC). It is given this description even though enteric media are incubated aerobically.
What are the Utilization/Fermentation tests?
Variety of systems developed to determine an organism’s ability to
metabolize a particular carbohydrate.
A single carbohydrate added to basal medium with pH indicator.
Some of carbohydrates tested include: Adonitol, Mannitol, Arabinose, Raffinose, Dulcitol, Salicin, Glucose •Sorbitol, Lactose, Sucrose, Maltose, Xylose.
NOTE: Some of these carbohydrates are sugars (e.g., lactose, glucose, and sucrose) while others are alcohols (e.g., mannitol, sorbitol, and dulcitol). Clinical microbiologists often lump
these carbohydrates together and simply refer to all of them as “sugars”.
Durham tubes sometimes used to detect gas production. A Durham
tube is a small tube placed upside-down in the test medium. If the
organism produces gas, gas bubbles are trapped in the Durham tube.